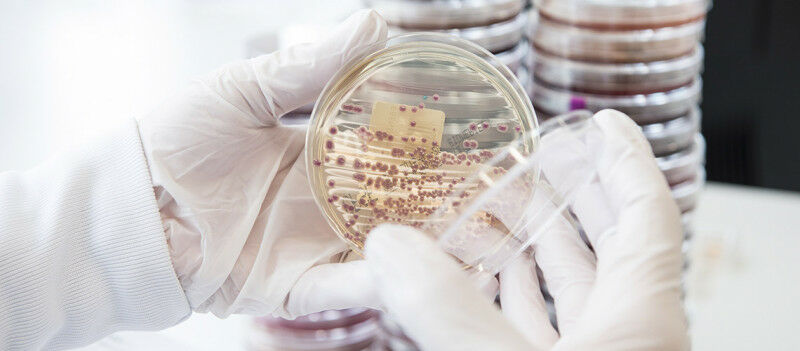
Antibiotic resistance: concerning situation in sub-Saharan African children

Focusing on enterobacteria, two studies by the University of Geneva and the HUG highlight the alarming situation in this region of the world in terms of antibiotic resistance.
Enterobacteriaceae are commensal bacteria of the digestive flora that can be responsible for serious infections. © HUG
Two meta-analysis undertaken by the Geneva University Hospital (HUG) and the University of Geneva have revealed very worrying numbers of children in Sub-Saharan Africa who are carriers of multi-resistant bacterial strains. The analyses have focused on Enterobacteriathe bacteria responsible for most invasive infections in new-borns in this region. The first study shows that 41% of Escherichia coli and 85% of Klebsiella bacteria found in the blood of children during infections are resistant to treatments normally used in severe childhood infections. The second study reveals that one third of children are colonized by cephalosporin-resistant Enterobacteria. Yet, if this treatment fails, alternative treatment options are often not available in this region. The two studies can be found in the journal eClinicalMedicine published by The Lancet.
Antibiotic resistance is a major concern for global health. The problem is particularly acute in Sub-Saharan Africa countries with the highest death rate due to antibiotic resistance, especially in West Africa where it exceeds 100 deaths per 100,000 people. Children and neonates are particularly vulnerable. As an example, 30% of new-borns suffering from sepsis, a severe inflammatory reaction following an infection, die due to antibiotic resistance.
Despite this situation, little epidemiological data exist on the effect of this affliction in children. Such data could, however, be crucial for the development of appropriate treatment recommendations. This is why a team from the HUG and UNIGE, led by Noémie Wagner, associate physician at the Paediatric Infectiology Unit of the HUG and privat-docent in the Department of Paediatrics, Gynaecology and Obstetrics at the University of Geneva Faculty of Medicine, and Annick Galetto-Lacour, associate physician at the Division of Paediatric Admissions and Emergency at the HUG and associate professor in the Department of Paediatrics, Gynaecology and Obstetrics at the University of Geneva Faculty of Medicine, carried out two meta-analyses.
Huge presence of resistant Enterobacteria in severe infections
The objective of the first study was to evaluate the proportion of antibiotic-resistant Enterobacteria in children with infections in Sub-Saharan Africa. These bacteria, often found in severe infections, are known for their ability to develop antibiotic resistance.
The research team started with a systematic review of 1,111 studies published between 2005 and 2022 on children with an infection. Of these, they retained 122 studies, then extracted published data from more than 30,000 blood, urine and stools samples from children between 0 and 18 to perform a statistical analysis known as a meta-analysis.
"We observed a strong proportion of antibiotic resistant bacteria, in particular those found in the blood of young patients," explains Noémie Wagner. The most common strains identified are Escherichia coli and Klebsiella spp. The study highlighted their considerable resistance to antibiotics, with high resistance proportions to ampicillin and gentamicin, first-line antibiotics recommended for sepsis. As for E. coli, these proportion reached 92.5% for ampicillin and 42.7% for gentamicin. Klebsiella spp strains are always resistant to ampicillin, and present resistance proportions to gentamicin of 77.6%. The Enterobacteria analysed also showed high proportions of resistance to third-generation cephalosporins, the second-line treatment for sepsis in children, with resistance proportions of 40.6% for E coli samples, and of 84.9% for Klebsiella samples. These results therefore suggest a very high level of resistance to first-line and second-line antibiotics recommended for treating child sepsis.
Too many child carriers
The aim of the second study was to estimate, also through a systematic study review and meta-analysis, the prevalence of children colonized by Enterobacteria resistant to third-generation cephalosporins. The term colonization denotes the fact of finding bacteria in a child’s stool when is no current infection.
40 studies out of the 1,111 were retained. Representing a cohort of 9,408 children, is the most extensive literature review to date for Sub-Saharan Africa. It revealed that 32.2% of children are carriers of Enterobacteria resistant to wide spectrum cephalosporins. "These proportions are very high and concerning. These treatments are indeed administered as second-line treatments when first-line treatments have failed. If it fails, treatment options are often not available in this region," explains Annick Galetto-Lacour.
The study also revealed that 53.8% of children who were not carriers of resistant Enterobacteria at admission to hospital, were positive for these bacteria when discharged.
Finally, this work showed that the risk of being a multi-resistant Enterobacteria carrier is three times higher after having received antibiotic treatment three months beforehand. Yet, in Sub-Saharan Africa, between 83% and 100% of hospitalized children are treated with antibiotics. "As bacterial infections are the main cause of death in this region, children are very often treated with antibiotics when they are admitted to hospital, even if there is no strong argument for a bacterial infection. Indeed, most medical facilities do not have access to inflammatory markers which can assist in distinguishing a bacterial infection, that requires antibiotics, from a viral infection. Nor do they have the possibility of using bacterial cultures and cannot therefore correctly identify bacterial species, nor perform antimicrobial susceptibility tests. It’s a vicious circle because the improper use of antibiotics increases the proportion of resistant bacteria, which then will be more difficult to treat," worries Dr. Wagner.
An alarming situation
These very high figures are alarming, specifically because they are significantly above past estimates. They highlight the urgent need for targeted actions to manage and control antibiotic resistance in Sub-Saharan Africa.
"Reducing antibiotic-resistance requires action on several fronts. These include reinforcing all possible measures aimed at an appropriate use of antibiotics and limiting the spread of infections through hygiene measures. Improved access to additional laboratory tests (inflammatory markers and bacteriological analyses) is also required to reduce the systematic utilization of antibiotics, to adapt treatments to the bacteria discovered, and to adjust recommended treatments to the resistance profile of the bacteria circulating in the region. In this context, the Mini-Lab developed by Médecins Sans Frontières is of particular interest. These are "all-in-one" clinical bacteriology laboratories which are autonomous, transportable and affordable. Finally, more prospective studies are required, including from more remote areas," concludes Noémie Wagner.
To find out more, read the article published in Scientific reports , that presents a new app that enables antibiotics to be classified based on their spectrum activity.



